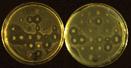

الدروس العملية |
الهدف والفكرة الأساسية
لكل درس |
الدرس العملي الأول

|
الأدوات المستخدمة فى معامل
الميكروبيولوجى
Tools Used in Microbiological Laboratories
يهدف هذا الدرس إلى تعرف الدارس على
العديد من الأدوات المطلوب إستخدامها فى
معامل الميكروبيولوجى ووظيفة كل منها حتى
يسهل عليه متابعة الدروس اللاحقة.
|
الدرس العملي الثاني

|
الأجهزة المستخدمة فى معامل
الميكروبيولوجى
Instruments Used in Microbiological
Laboratories
يستهدف هذا الدرس تعريف الدارس بالعديد من
الأجهزة التى من الضرورى إستخدامها فى
معامل الميكروبيولوجى
،
مع التركيز على تعريفه بالأنواع المختلفة
من الميكروسكوبات
،
وتنمية مهارته فى إستخدام الميكروسكوب
الضوئي (المركب) لفحص التحضيرات
الميكروبيولوجية المختلفة بهدف التعرف على
أشكال البكتريا والميكروبات الأخرى التى
يتعامل معها. |
الدرس العملي الثالث

|
البيئات البكتيريولوجية
Bacteriological Media
يستهدف هذا الدرس إكساب الدارس مهارة
إختيار البيئة الغذائية الملائمة لتنمية
البكتيريات بأنواعها المختلفة بغرض ضمان
نجاح نموها على المستوى المعملى والصناعى
، حيث أن الإختيار غير الجيد لمكونات
البيئة أو إحتوائها على عناصر ثقيلة أو
سموم أو مواد ذات ضغط إسموزى عالى قد يؤدى
إلى نمو محدود للكائن الحى وإعطائه نتائج
غير مرضية . |
الدرس العملي الرابع

|
التعقيم Sterilization
يستهدف هذا الدرس تعريف الطالب بالأدوات والأجهزة المستخدمة
فى التعقيم ، وتعريفه بكل طريقة من الطرق
المستخدمة فى تعقيم المواد والأدوات
المطلوبة - فى معامل الميكروبيولوجى وفى
مصانع الأغذية والمنتجات الغذائية - بحالة
خالية من التلوث الميكروبي ، وكذلك تنمية
مهارة الدارس فى استخدام وسائل التعقيم
المختلفة حتى يكون مؤهلاً للعمل فى السوق
الخارجى بكفاءة عالية. |
الدرس العملي الخامس

|
المزارع البكتيرية
Bacterial cultures
يستهدف هذا الدرس تنمية معرفة الطالب
بأنواع المزارع البكتيرية والإجراءات
اللازمة للحصول عليها فى صورة نقية وكيفية
التدريب على كيفية إستعمال الحضان لتوفير
درجة الحرارة المناسبة لنمو الميكروب
بالإضافة إلى الإحتياطات الواجب مراعاتها
عند إستخدام الحضان. حيث أن كل ذلك يؤهل
الطالب للعمل فى معامل البكتريولوجى -
المتحصصة فى إنتاج البادئات والمحافظة
عليها من التلوث والتدهور - الملحقة
بمصانع الأغذية والألبان وكذلك مصانع
إنتاج الأسمدة الحيوية والأسمدة العضوية
الصناعية (الكمبوست).
|
الدرس العملي السادس

|
إنتشار الميكروبات فى
الطبيعة
The spreading of microorganisms in
nature
يستهدف الدرس الحالى التعريف بطبيعة
الإنتشار الميكروبى فى الطبيعة ، فالميكروبات
توجد
فى
كل
مكان تقريباً ،
ويندر أن يوجد مكان يخلو منها
على سطح كوكب الأرض الذى نقطنه ،
وتتباين الأعداد والأنواع الموجودة في كل
مكان عن الآخر تبعاً للظروف التي تناسب كل
منها سواء من حيث نوع الغذاء أو نسبة
الرطوبة أو درجات تركيز أيون الأيدروجين
أو ظروف التهوية
…الخ ،
وللتأكد من ذلك يجرى التدريب التالي
لإختبار مدى وجود الميكروبات فى
الهواء وفى التراب وعلى الجلد وفى ماء
الصنبور . |
الدرس العملي السابع

|
عزل
وتنقية
البكتيريا
Isolation and Purification of bacteria
لا توجد
الأنواع
البكتيرية
فى
الطبيعة منعزلة
كلٍ
على حده ،
بل توجد مختلطة مع بعضها
،
ولدراسة خواص كل نوع يتحتم عزله بحالة
نقية بحيث لا يصبح في المزرعة إلا نوع
واحد من الميكروبات وهو المراد دراسته
،
وتجرى عملية العزل بعدة طرق منها
:
1- طريقة
الأطباق المصبوبة
Pouring plate method
:
2- طريقة
الأطباق المخطوطة
Streaking plate method
: |
الدرس العملي الثامن

|
حاجة البكتيريا للأكسجبن
Oxygen Requirement for Bacteria
يستهدف هذا الدرس التعرف على علاقة
الأكسجين الحر بنمو الميكروبات ، والتدريب
على طرق إنماء الميكروبات اللاهوائية ،
فأنواع البكتيريا تختلف كثيراً فى
إحتياجاتها للأكسجين الغازى ، فبعضها
لايستطيع النمو فى غياب الأكسجين (
هوائية إجباراً
Strict aerobes) ، وبعضها لايستطيع النمو فى غياب الأكسجين (لاهوائية
إجباراً
Strict anaerobes)
، فى حين ينمو البعض الآخر فى وجود وغياب
الأكسجين (لاهوائية
إختياراً
Facultative anaerobes) ، وهناك بكتيريات محبة للهواء بنسبة قليلة
Microaerophiles إذ تحتاج للأكسجين الحر لكن بتركيز محدود للغاية ، أما البكتيريات
المتحملة للهواء
aerotolerant فهى تلك البكتيريا اللاهوائية التى تتحمل ،
وتستطيع النمو فى وجود نسبة من الأكسجين
أقل من تلك الموجودة بالجو العادى. |
الدرس العملي التاسع

|
الصبغ البسيط
Simple stain
يستعمل الصبغ البسيط للتعرف على شكل
الميكروب ونظام تجمعه. والصبغات الشائعة
الإستعمال هى:
1- صبغة الفوكسين المخفف
fuchsin
أو السفرانين
Safranin:
وهى من مشتقات الإنيلين ولونها أحمر, ومدة
التعرض لها (1/2 -1) دقيقة.
2- صبغة أزرق الميثيلين methylene blue
: وهى صبغة ضعيفة نسبياًَ ومدة التعرض لها
(3-5) دقائق. |
الدرس العملي العاشر

|
الصبغ بطريقة جرام
Gram Stain Method
تهدف هذه الطريقة من الصبغ إلى تدريب
الطالب على أهم طرق الصبغ المستخدمة فى
تمييز الميكروبات والتفرقة بينها لسهولة
التعرف عليها.
أهمية هذه الطريقة من الصبغ :
1- تعتبر هذا الطريقة من أهم الطرق
المستعملة للتفرقة بين أنواع البكتيريا إذ
بواستطها يمكن وضع البكتيريا فى إحدى
المحموعتين الآتيتين :
أ- البكتيريا الموجبة لصبغة جرام (G+)
Gram positive bacteria.
ب- البكتيريا السالبة لصبغة جرام (G-)
Gram negative bacteria.
2- لها أهمية كبيرة للحكم على مدى نقاوة
المزرعة البكتيرية. |
الدرس العملي الحادي عشر

|
صبغ الجراثيم البكتيرية
Staining of Bacterial Spores
تكوّن بعض أنواع من البكتيريا أجساماً ذات
جدر غليظة واحدة فى كل خلية تسمى
بالجرثومة
spore . والجرثومة أقل قابلية للصبغ عن الخلايا الخضرية بسبب
جدارها السميك وتمكاسك بروتوبلازمها نتيجة
نقص الماء فيه ، فإذا صبغت الخلايا
البكتيرية المحتوية على الجراثيم بالصبغات
العادية فإن الجرثومة لا تصبغ وتظهر كبقعة
رائقة لامعة بينما تصبغ بقية الخلية بلون
الصبغة المستعملة ، إلا أنه عند صبغ
الجراثيم بطرق خاصة (كإستعمال صبغة مركزة
مع التسخين) فإنها تحتفظ بالصبغة ويتعذر
إزالتها منها ، أما الأجزاء الخضرية من
الخلية فتزال منها الصبغة عند غسلها
بالماء فيسهل صبغها بعد ذلك بإحدى الصبغات
المضادة البسيطة وهناك عدة طرق لصبغ
الجراثيم من أهمها طريقة شيفروفلتون. |
الدرس العملي الثاني عشر

|
صبغ البكتيريا المقاومة (الصامدة) للأحماض
Staining of Acid Fast Bacteria
توجد بعض أنواع من البكتيريا تكسو جدرها
الخلوية طبقة دهنية أو شمعية لا تسمح
للصبغة بتخللها عند الصبغ بالطرق البسيطة
أو المعتادة، ولهذا يستخدم لصبغها طرق
خاصة يستعمل فيها محلول صبغة قوية يحتوى
على مثبت للون
Mordant
كالفينول ويترك عليها مدة طويلة أو يسخن
قليلاً. ومتى صبغت هذه الأنواع من
البكتيريا تثبت فيها الصبغة ويتعذر
إزالتها منها حتى بإستعمال كحول مضاف إليه
حامض (الكحول الحامضى
acid alcohol)،
ولهذه الخاصية أطلق عليها لفظ الصامدة أو
المقاومة للأحماض
(acid fast). |
الدرس العملي الثالث عشر

|
صبغ الغلاف البكتيرى (الكابسول أو العلبة)
Staining of Bacterial Capsule
تتميز بعض أنواع البكتيريا بوجود أغلفة
عبارة عن مواد هلامية كربوهيدراتية تحيط
بالخلايا ، وعند صبغ هذه البكتيريا
المغلفة بصبغة عادية فإن الغلاف يظهر
كطبقة خفيفة اللون تحيط بالخلية البكتيرية
المصبوغة بشدة. ونظراً لأن الغلاف قابل
للذوبان فى الماء فيجب عدم إستعمال الماء
بقدر الإمكان أثناء الصبغ حتى لا يزول
الغلاف ، كما لا يجب إستخدام الحرارة عند
تجفيف الغشاء المجهز لهذه الأنواع من
البكتيريا حيث أن الغلاف يتلف بالحرارة.
ومن بين الطرق المستخدمة لصبغ الغلاف أو
الكبسول تستخدم طريقة أنتونى. |
الدرس العملي الرابع عشر

|
الصبغ السالب
Negative Stain
يعتبر تكنيك الصبغ السالب للأغشية
البكتيرية ذات أهمية كبرى فى تمييز
البكتيريا ، وتستخدم هذه الطريقة عند
الرغبة فى قياس حجم البكتيريا حيث تظهر
الخلايا بحجمها الطبيعي لعدم إستخدام
الحرارة مطلقاً أثناء إجراءات الصبغ بهذه
الطريقة ، كما تستخدم هذه الطريقة لدراسة
الشكل الظاهرى للبكتيريا . وتسمى بالصبغة
السالبة لأنه يتم صبغ الشريحة دون الخلايا
البكتيرية ، فتظهر الخلايا شفافة غير
مصبوغة ، بينما بقية الشريحة تظهر ملونة .
ويرجع السبب فى عدم تخلل الصبغة جسم
الخلية هو أن الصبغة المستخدمة تكون ذات
جزيئات كبيرة لا تنفذ خلال الجدار الخلوى
(مثل الحبر الهندى
India ink)
، أو قد تكون صبغات حامضية عديمة أو قليلة
التأثير على محتويات البروتوبلازم
القاعدية (مثل النيجروسينNigrossin).
|
الدرس العملي الخامس عشر

|
قياس حجم البكتيريا
Measurement of Bacterial Size
لطول وعرض أو قطر الخلايا البكتيرية أهمية
فى تمييز أنواعها، إذ تختلف أنواع
البكتيريا فى طولها وعرضها وقطرها ، ولذا
يعتبر قياس حجمها من ضمن الطرق
المورفولوجية للتعرف عليها . وتختبر
البكتيريا المراد قياسها إما بإستعمال
إختبار النقطة المعلقة أو بإستخدام
الأغشية المصبوغة ، ولو أن تجفيف الغشاء
وتثبيته يسببان إنكماشها ، ومن الأفضل
إستخدام تكنيك الصبغ السالب عند الرغبة فى
الحصول على الحجم الحقيقي للبكتيريا .
ووحدة القياس المستعملة لقياس حجم الخلايا
هى الميكرون وهو يساوى 1/1000 من
الميليميتر . ولقياس حجم البكتيريا تستعمل
عدسة عينية خاصة مجهزة بميكروميتر
Micrometer أى مقياس مدرج وتسمى العينية الميكرومترية. |
الدرس العملي السادس عشر

|
دراسة الحركة فى البكتيريا
Study of Bacterial Motility
تنمية مهارة الدارس فى التعرف
على البكتيريا من خلال إكسابه القدرة على
إجراء إختبار حركة البكتيريا كأحد الفروق
التمييزية الهامة بين الميكروبات ، حيث
تنقسم البكتيريا من حيث قدرتها على الحركة
إلى مجموعتين هما البكتيريا المتحركة وغير
المتحركة. |
الدرس العملي السابع عشر

|
دراسة تأثير بعض العوامل على نمو البكتيريا
Some Factors Affecting Bacterial Growth
يهدف هذا الدرس إلى زيادة معرفة الطالب بالظروف
التى تؤثر على نمو البكتيريا ، وكيفية
تهيئة أنسب هذه الظروف للحصول على أعلى
نمو، للمزارع البكتيرية والمحافظة عليها
من التدهور ، وكذلك تدريب الطالب على
|
الدرس العملي الثامن عشر
|
دراسة النشاط الإنزيمى للبكتيريا
Study of Enzymatic Activity of Bacteria
يستهدف هذا الدرس التعرف على بعض
الإنزيمات التى تمتلكها الميكروبات والتى
يمكن عن طريقها التعرف على الميكروبات
وتمييزها عن بعضها البعض.
|
الدرس العملي التاسع عشر

|
ميكروبيولوجيا المياه
Water Microbiology
يعتبر الماء من الأهمية بمكان لكل
الكائنات الحية علي سطح الأرض،
حيث أنه مصدر الحياة,
لذلك قال الله تعالي في كتابه
الكريم
(وجعلنا
من الماء كل شيء حي).
والمياه التي
هى
مصدر
الحياة
يجب
ألا
يكون
لها لون
أو
طعم
أو
رائحة,
ولكن إذا تطرق إليها التلوث فإن
ذلك يسبب تغيراً
في اللون أو الطعم أو الرائحة أو كل
هذه
الصفات. |
الدرس العملي العشرون

|
ميكروبيولوجيا الألبان
Dairy Microbiology
يؤخذ العدد البكتيري الكلي
Total bacterial count في عينة لبن كدليل هام علي ظروف إنتاجه وتداوله ومقدرته علي
الحفظ
Keeping quality ، فزيادة الميكروبات باللبن الخام يدل علي تلوثه بدرجة
كبيره أثناء الإنتاج والتداول خاصة إذا ما
تم تداوله بدون تبريد. هذا وقد يحتوي
اللبن علي عدد كبير من البكتيريا دون أن
يظهر عليه أي تغير غير طبيعي لأن التغير
لا يتم إلا إذا وصلت أعداد الميكروبات إلي
حد معين ، كذلك يعتبر نوع البكتيريا دليل
مهم علي تحديد مصدر التلوث ونوع الفساد.
ويستهدف هذا الدرس تدريب الطالب على فحص
عينة لبن من الناحية البكتيريولوجية من
حيث أعداد البكتيريا والتغيرات التى
تحدثها فى اللبن من خلال بيئة لبن عباد
الشمس حتى يكتسب الخبرة التى تمكنه من
العمل فى المعامل البكتيريولوجية الملحقة
بمصانع الألبان. |
الدرس العملي الحادي العشرون

|
ميكروبيولوجيا الأراضى
Soil Microbiology
تعتبر التربة الخصبة وسطاً مناسباً لنمو
الكثير من أنواع الكائنات الحية الدقيقة
من بكتيريا وفطريات وطحالب وفيروسات
وبروتوزوا . والكثير من هذه الكائنات
الحية لها دور حيوي وهام فى خصوبة التربة
نظراً لما تقوم به من تحولات بيولوجية .
ولهذا يستهدف هذا الدرس إكساب الدارس
مهارة التعرف على الإختلافات فى أشكال
الميكروبات التى تسكن التربة وتنمية
مهارته فى إستخدام بعض الطرق المستعملة فى
عد ميكروبات الأراضي وكيفية عزل بعض أنواع
البكتيريا ذات الصلة بخصوبة التربة ،
وبالتالى يكتسب خبرة إنشاء مشاريع صغيرة
لتحضير الأسمدة الحيوية ، وكذلك خبرة
الحصول على سلالات عالية الكفاءة فى تحليل
المواد العضوية تساعد على سرعة إنضاج
السماد العضوى الصناعى (الكمبوست).
|
الدرس العملي الثاني والعشرون

|
الفساد الميكروبى للغذاء
Microbial Spoilage of Food
تعتبر المواد الغذائية وسطاً مناسباً لنمو
وتكاثر أنواع مختلفة من الميكروبات والتى
قد تصل إليها بوسائل عديدة ، ومن أهم
الميكروبات التى تصل إلى الأغذية البكتريا
والفطريات والخمائر والفيروسات والتى قد
تسبب فى معظم الأحيان فساداً لتلك الأغذية
سواء كانت طازجة أو حتى محفوظة. ويتوقف
نوع الفساد الحادث على نوع الميكروب
المسبب ، وكذلك على تركيب الطعام وخواصة
الطبيعية ، والظروف المحيطة ، وغيرها من
العوامل. ويستهدف هذا الدرس إكساب الدارس
مهارة فحص الأغذية بأنواعها المختلفة سواء
كانت فاكهة أو خضر أو أغذية مصنعة من حيث
فسادها أو عدمه وتحديد نوع الفساد الحادث
بها والمسبب الميكروبى لهذا الفساد ،
وبالتالى يمكن إستفادته من المهارة التى
إكتسبها للعمل فى معامل الميكروبيولوجى
الملحقة بمصانع الأغذية. |